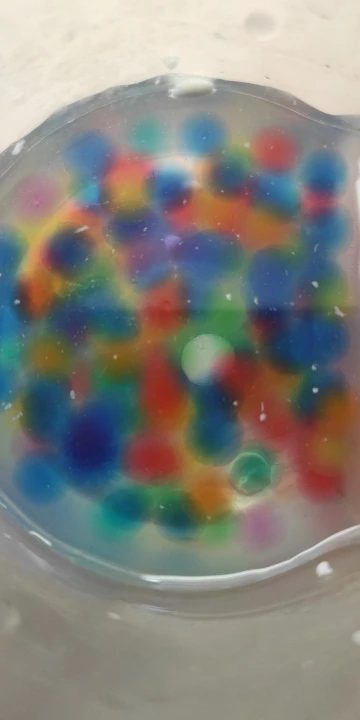

4 стиля в форме жемчуга кристалл почвы грязь гидрогель растущий блеск Orbiz Водяные Шарики, водяные бусины набор домашний декор 




Day Day Up E-Market - Надежность 90.75%
Более 2612 подписчиков, дата открытия магазина 14.09.2015
- Положительные оценки: 93% (1076)
- Соответствие описанию: 92%
- Отвечает на сообщения: 90%
- Скорость отправки: 88%
Последнее обновление: 15.09.2024
Отзывы покупателей
Покупатель
Страна: SG Доставка: Standard Shipping 29.10.2020
Вроде неплохо, но большие лопаются сами по себе. Написано 5-7 дней в воде держать, на второй лопнули, были полностью под водой. Как бы внутренний слой впитал больше воды, чем наружный, и их разорвало. Один сразу, другой при касании. Ну и те, которые в темноте- сухие светятся не все, одни ярко, другие почти никак.
Z***n
Страна: RU Доставка: Standard Shipping 08.12.2020
спасибо большое за быструю доставку.Пришол меньше чем за месяц.Ребенок доволен
A***v
Страна: RU Доставка: Standard Shipping 16.03.2021
отличная игрушка для детей!
I***o
Страна: RU Доставка: Standard Shipping 14.01.2021
Добрый день ,товар пришёл быстро, продавца советую
Покупатель
Страна: ES Доставка: Standard Shipping 19.01.2021
Todo perfecto, igual que la descripcion, es lo que esperaba. Envio rаpido, vendedor muy recomendable. Volveria a comparar все идеально, как и в описании, это то, что я ожидал. Быстрая доставка, настоятельно рекомендуем продавцу. Покупал бы снова
A***a
Страна: UA Доставка: Seller's Shipping Method 11.10.2020
Хороший, но большие шарики легко разрушить, остальное все хорошо. Спасибо вам
Покупатель
Страна: CA Доставка: Seller's Shipping Method 13.03.2021
Хорошо!
A***z
Страна: PE Доставка: Standard Shipping 07.03.2021
Хороший продукт.
E***a
Страна: ES Доставка: Standard Shipping 08.02.2021
Ок
N***k
Страна: UA Доставка: Standard Shipping 05.11.2020
Конечно наполняемость пакетика не такая как на фото. но посмотрим.
Покупатель
Страна: FR Доставка: Standard Shipping 28.03.2021
Sympa.